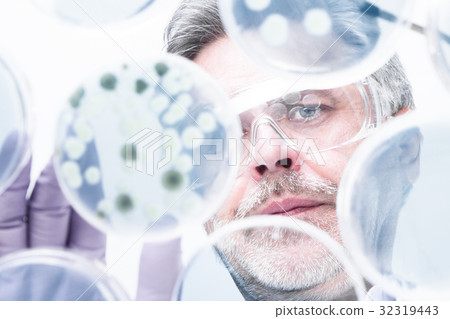

優惠套餐
照片素材(圖片): Senior life science researcher grafting bacteria.
素材編號 : 32319443 查看全部
Senior life science researcher grafting bacteria.[32319443],此圖庫照片素材(圖片)具有科學,實驗室,研究的關鍵詞。此照片素材是kasto / (No.358441)的作品。您可以購買圖小從影像尺寸從S至LUS$5.00以上的尺寸。註冊成為免費會員後,您可以下載帶有浮水印的圖片以確認畫質及使用收藏夾的服務。 查看全部